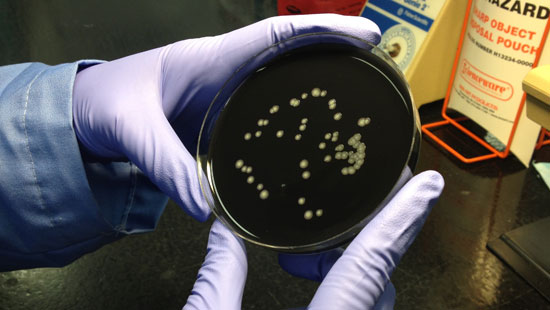
Bacteria Slide

军团杆菌控制策略
通过与各行各业开展合作,我们成为独立的水安全专家,每年消毒超过10亿加仑饮用水。如果您的水管理计划需要控制策略,我们具备缓解和降低工厂风险所需的工具与专业技术。
病原体分析
军团杆菌测试用于验证您控制措施的有效性。纳尔科拥有通过纽约卫生署ELAP(环境实验室核定计划)认证的私人军团杆菌实验室,并且是在环境样本中培养军团杆菌方面持有熟练操作证书的US-CDC ELITE成员。纳尔科的实验室遵照ISO 11731针对军团杆菌识别和技术的培养方法。我们还支持其他水生病原体的培养测试,而且我们可帮助您解释测试结果。


短期修复
纳尔科可针对多种类型的用水系统提供修复服务,包括冷却塔、饮用水系统、装饰水景和饮用水储水箱。修复不仅涉及清洁和化学消毒,同样包括提供适当的文件以验证工艺流程是否完成。我们的修复服务可以提前安排,也可在出现紧急情况时应要求提供。纳尔科长期以来一直提供例行和紧急修复服务,帮助您的工厂修复水系统以重新获得控制并降低风险。
长期控制策略
如果验证和确认步骤证明某个系统的微生物生长风险较高且无法使用例行工程控制或短期修复策略进行管理,那么您的工厂就可能需要长期控制策略。我们将基于风险评估的发现,推荐风险缓解策略,包括补充消毒和饮用水系统使用点水过滤或各种冷却塔消毒程序。

补充消毒
补充消毒依然被视为限制建筑生活用水系统中微生物生长的最佳策略。生活用冷水和热水系统可提供病原体生长的理想条件,而由于系统复杂性,这些问题可能难以解决。纳尔科了解冷水和热水系统补充消毒的复杂性。我们已开发出二氧化氯或氯气现场生成技术以应对这些独特的挑战。这些系统由我们屡获殊荣的3D TRASAR™补充消毒技术进行控制与监测,包括24/7客户保证中心。

使用点水过滤
安全用水对于医疗保健和酒店设施而言至关重要。纳尔科可在紧急情况下采用使用点水过滤,为实施修复措施争取时间,也可用作高危或重症患者护理的长期控制策略。这些过滤器可用于沐浴淋浴、水槽、制冰机或其他水设施。指定滤水器的过滤器寿命可达到14天、31天或62天。

冷却塔的水安全协议
由于近期的军团杆菌爆发与冷却塔直接相关,因此了解降低冷却塔军团杆菌风险的“内容”和“方法”至关重要。无论是NY法规还是理解业内接受的最佳实践,纳尔科都将帮助您指定合适的解决方案以实现合规并管理运营风险。纳尔科提供全套水安全解决方案,包括军团杆菌测试、冷却塔检验、线上消毒、线下清洁和消毒以及实施侧重于冷却塔的水管理计划。